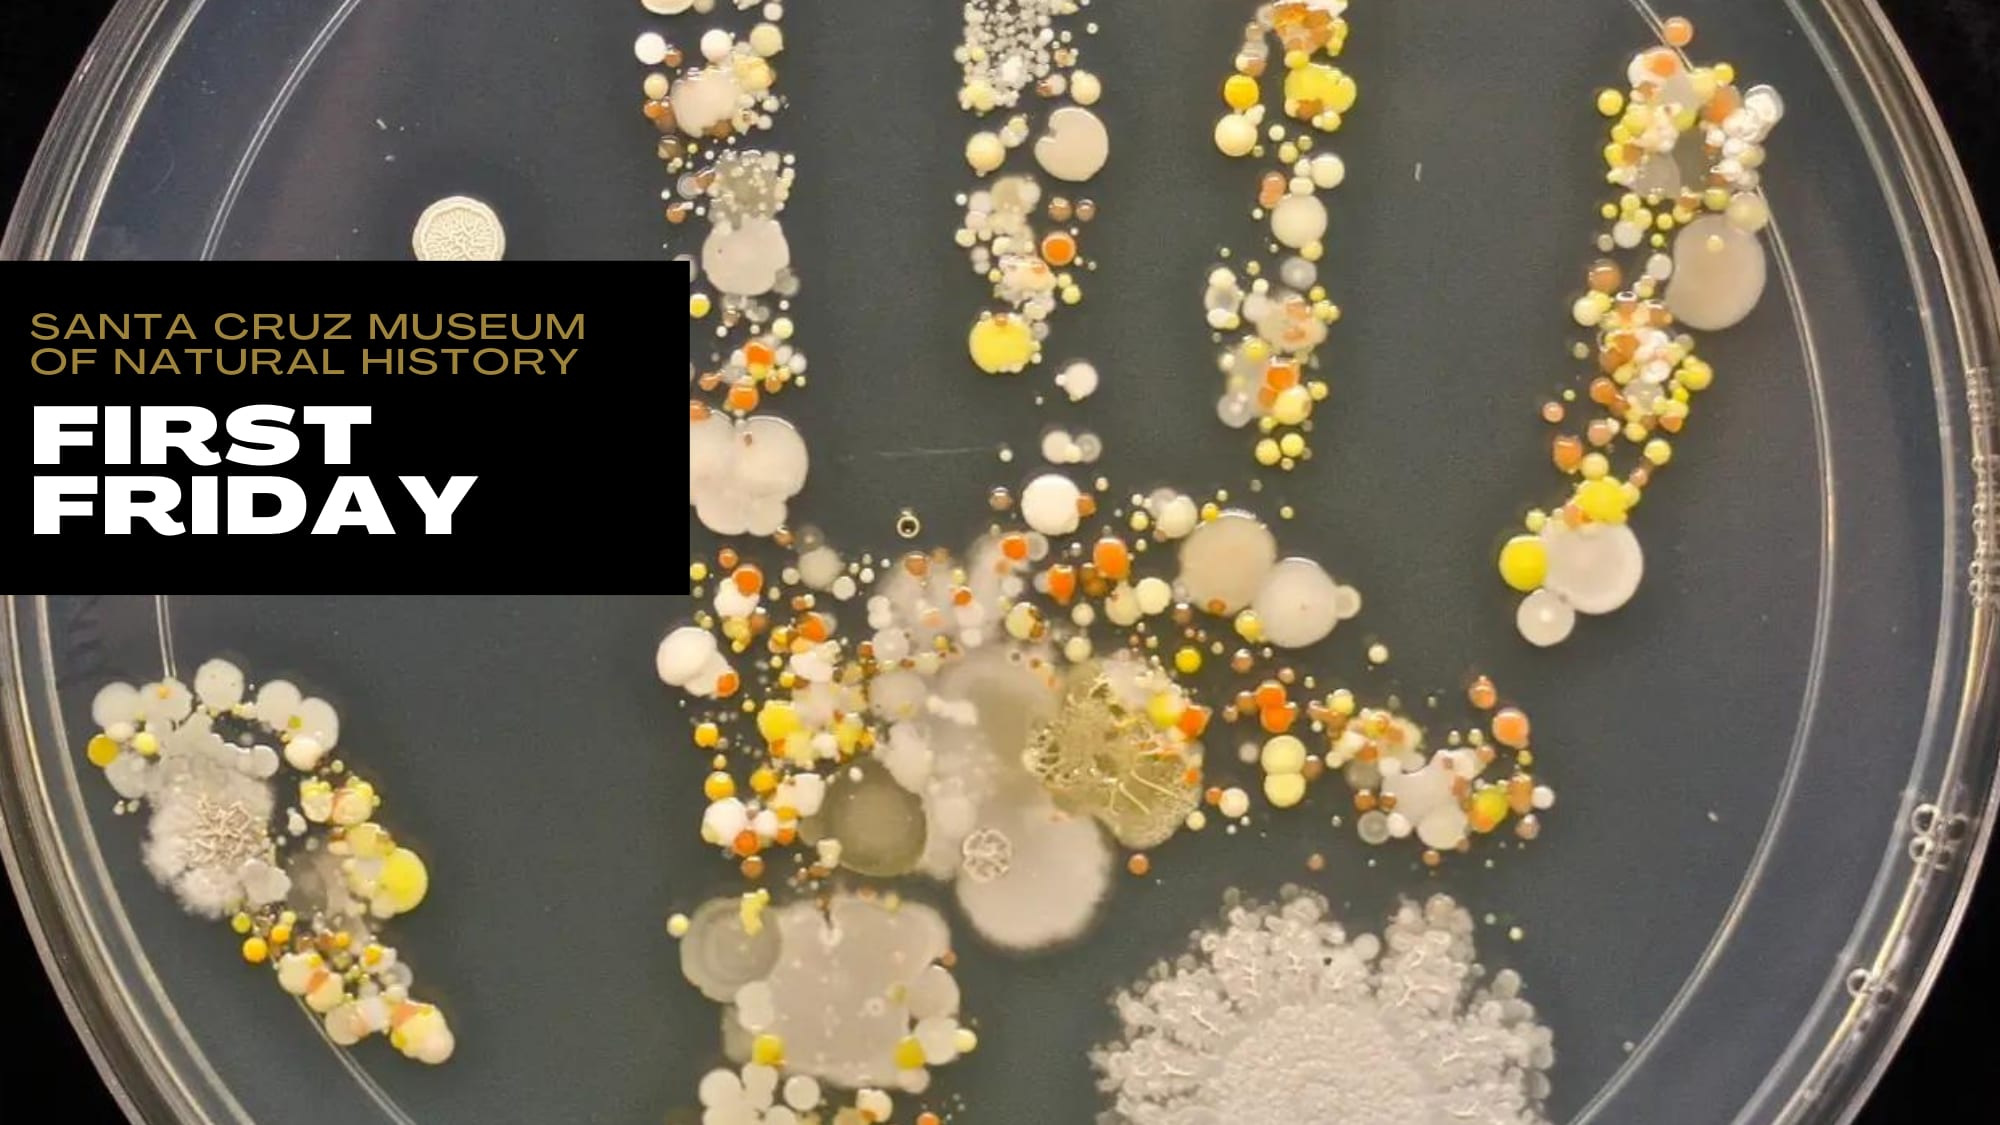
inception-app-prod/MzNhYTIwZTEtOWI0MC00ODk3LWFjODAtYmZhOTNmNmUxNjVj/content/2022/06/d7275d23a4ccee6b8fad8e76fc5c583a4effc7a3.png

7/1 First Friday After Hours | MICRO
Nerd out on your night out! π₯π» Join us for special after hours events every First Friday.
Free admission all day, with special outdoor festivities 5-8 p.m.

Julyβs First Friday event will zoom into the microscopic world around us. Join local scientists and foodies for activities and displays that highlight the unseen. Food from Areperia 831 and adult drinks will be for sale. Featuring:
- Cabrillo College
- UCSC Microbiology and Environmental Toxicology
- Equinox Wine
- Driscollβ
- UCSCβs Women in Science and Engineering
Friday, July 1, 2022
5-8 p.m.
Location: Outside the Santa Cruz Museum of Natural History
Accessibility
- Drop-by anytime 5-8 p.m. to join the festivities!
- Admission to the Museum is free all day from 11 a.m. to 8 p.m.
- Follow the latest guidelines for for covid safety.
- Restrooms and water fountains are available inside the Museum.
- Activities will be on somewhat lumpy grass.

Source: Santa Cruz Museum of Natural Historyhttps://www.santacruzmuseum.org/7-1-first-friday-micro/
OPEN HOUSE β 444 Whispering Pines Drive #86